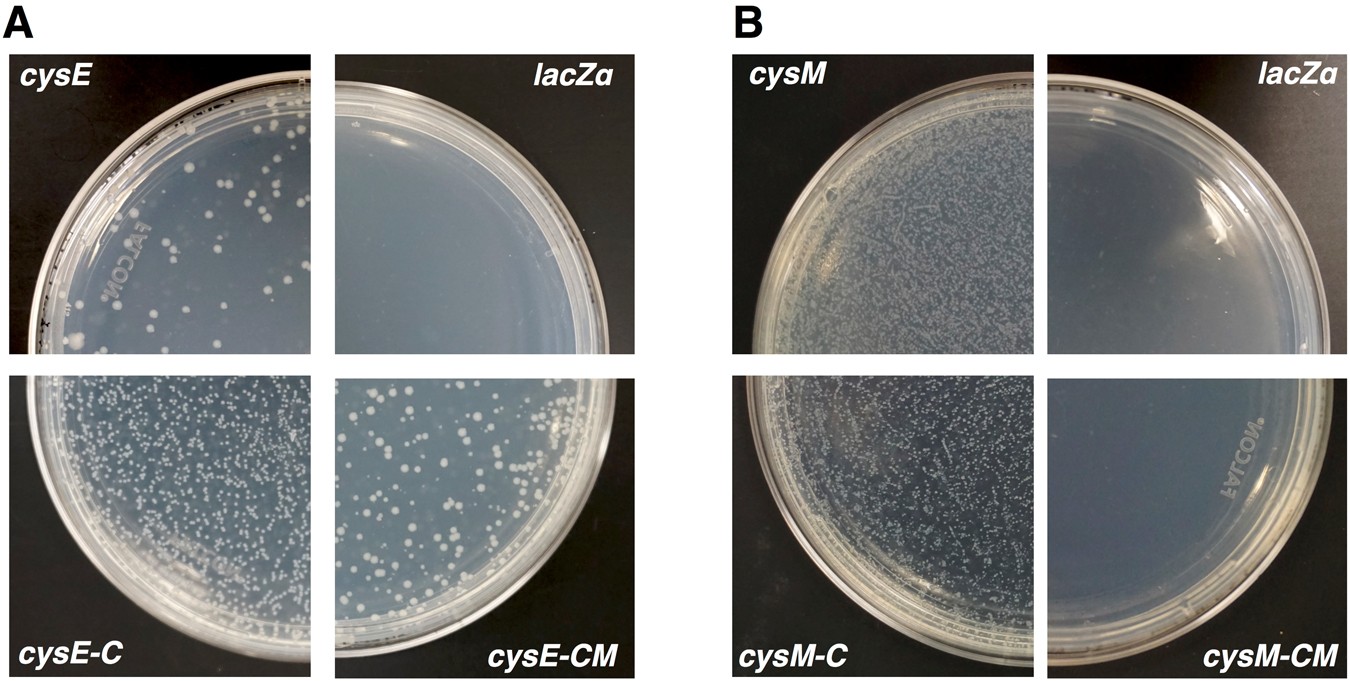
Figure 5

Figure 5
From: Reconstruction of cysteine biosynthesis using engineered cysteine-free enzymes
Growth curve of re-transformed auxotrophic E. coli strains in LB and M9 + glucose media. Each panel represents growth of cysteine-dependent E. coli auxotrophs rescued by wild type enzymes: CysE or CysM (blue), cysteine-free enzymes: CysE-C or CysM-C (orange), cysteine- and methionine-free enzymes: CysE-CM or CysM-CM (yellow), and LacZα protein expressed from original pUC19 plasmid (gray). Growth curve was monitored every 10 minutes at OD 600 nm using 96-well plate reader. Standard deviations of the growth curves are displayed as calculated from triplicates.